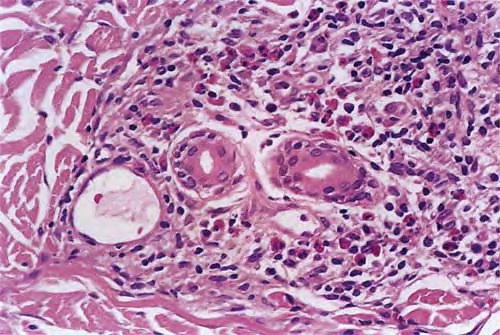

Arsenical keratoses = التقران الزرنيخي
Arsenical keratoses = التقران الزرنيخي ARSENICAL KERATOSES Arsenical keratoses (ArKs) are precancerous lesions found in association with chronic arsenicism. These lesions have the potential to develop into invasive SCC. Arsenic is a ubiquitous element that has no color, taste, or odor. It has the potential to cause characteristic acute and chronic syndromes in persons exposed […]
Read More